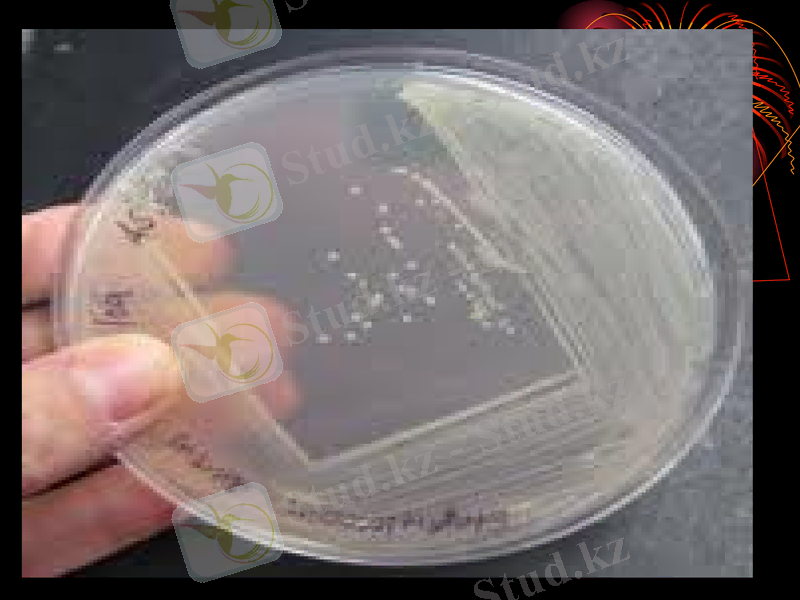
Slide 6
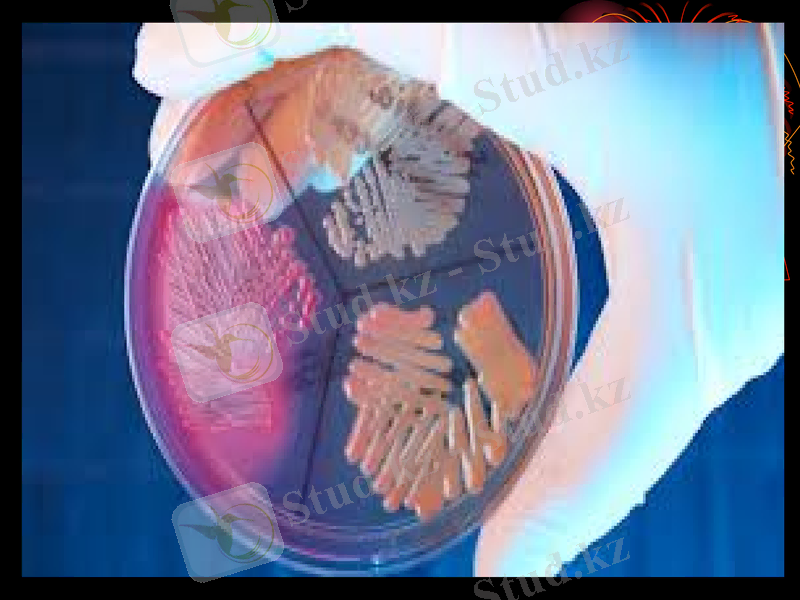
Slide 7
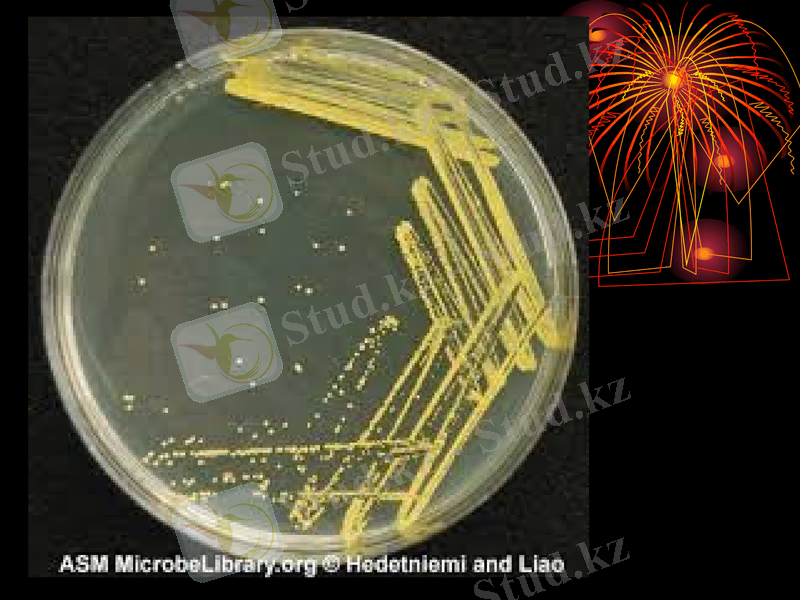
Slide 14

Коктар мен стафилококтар: морфология, патогенез, клиника, диагностика және алдын алу




Коктар Cтафилококтар
Орындаған: “Бактерия” тобы
Қабылдаған: Асанова Ғ
Тобы: ЖМ - 203

Осы топқа адамдарға патогенді және шартты патогенді дөңгелек пішінді бактериялар жатады. Араларында қатаң анаэробтар (стафилококтар, пептострептококтар, нейссериялар), аэробтар Және микроаэрофилдер (стафилококтар, стрептококтар, нейссериялар) бар. Коктар арасында грам оң және грам теріс бактериялар бар. Олардың барлығы адамда ауырлығымен және орналасуымен ерекшеленетін іріңді қабыну үрдістерін туғызады.

Стафилококтар Staphylococcus туыстығына жатады, оған медицинада маңызды 3 түрі кіреді:
Staphylococcus aureus
S. epidermidis
S. saprophyticus

Аэробты грам оң коктар
Аэробты және факультативті грам оң коктар тобына екі қасиет тән: сфералық пішіні және грам оң боялуы. Олар спора түзбейді, қозғалмайды. Медицинада маңызды орынды екі тұқымдастық алады: Місгососсасеае және Streptococcaceae. Олар бір-бірінен цитохром және каталазалық белсендігі бойынша ажыратылады.

Місгососсасеае тұқымдастығы
Місгососсасеае тұқымдастығы өкілдерінің арасында адамда ауру тудыратын қоздырғыштарға Місrococcus, Staphylococcus, Stomatococcus туыстастықтарының өкілдері кіреді

Стафилококтар (Staphylococcus туыстастығы)
Стафилококтарды Л. Пастер және Огстен (1880 ж. ) ашқан. 1884 жылы Розенбах стафилококтардың толық сипаттамасын берген. Байрд-Паркер жіктеуі бойынша Staphylococcus туыстастығының 3 түрі кездеседі. Staphylococcus aureus, S. epidermidis, S. saprophyticus. Соңғы кезде ұсынылған жіктеуде стафилококтардың көптеген түрлері бар - S. haemolyticus, S. hominis, S. warneri, S. capitis, S. saccharolytcus, S. pasteuri, алайда олар тек ғылыми зерттеулерде ғана қолданылады.

Морфологиясы.
Стафилококтардың барлық түрлері шар тәрізді, дұрыс пішінді диаметрі 0, 5 - 1, 5 мкм жасушалар, грам оң боялады, кеңістікте дұрыс емес бөлініп жүзім шоғырына ұқсас шоқтық түзеді. Жалғыз және қосақталған жасушалар да кездеседі. Спора түзбейді, талшықгары жоқ. Кейбір штамдары капсула түзеді. L-пішін түзуі мүмкін. Жасуша қабырғасында рибитолтейхой және глицеролтейхой қышқылдары және А протейінімен байланысқан жасуша қабырғасында көптеген пептидогликандар кездеседі. S. аигеus-тің А ақуызы адамның және көптеген сүтқоректі жануарлардың LgG Fс-фрагментімен байланысады. Көптеген стафилококтар беткей орналасқан капсула түзеді.


Дақылдандыру
Стафилококтар қарапайым ортада (рН 7, 0-7, 5) өседі және факультативті анаэробтар, хемоорганотрофтар. Каталазасы бар, оксидазасы жоқ. Аэробты жағдайда өсіргенде амин қышқылдар және витаминдерді, анаэробты жағдайда - қосымша урацил және көмірсуларды қажет етеді. Жоғары осмостық қысымға төзімді, соған байланысты стафилококтар құрамында тұздың жоғары концентрациясы бар электативті қоректік орта - сарыуызды - тұзды агар немесе сүтті -тұзды агарда өсе алады.
Қанды агарда колониялар айналасында гемолиз аймағы пайда болады. Сұйық қоректік ортаны стафилококтар біркелкі лайландырады, кейін кілегейлі тұнба пайда болады.

Ферменттік қасиеті.
Биохимиялық белсенділігі жоғары: көптеген штамдары глюкозасы бар ортада ацетоин түзеді (Фогес-Проскауэр реакциясы оң), аммиак бөледі, нитраттарды нитритке немесе азотқа дейін қалыпқа келтіреді, ақуыздарды, гиппуратты, майларды және твиндерді гидролиздейді. Тек staphylococcus туыстастығына тән қасиет - анаэробты жағдайда глюкозаны қышқылға дейін ыдыратуы, филококтардың микрококтардан айырмашылығы болып келеді.

Антигендік қасиеті.
Стафилококтардың антигендік құрылымы өте күрделі және құбылмалы. Ақуыз, "огликан, тейхой қышқылынан, капсуласынан тұратын антигендері белгілі. Түрлік арнайы антигені тейхой қышқылдарымен байланысты: S. aureus-те - рибитолтейхой қышқылы, S. epidermidis-те - глицеринтейхой қышқылы, S. saprophyticus-та тейхой қышқылының екі түрі де анықталады. А протеин молекуласының Ғс фрагментімен тығыз байланысады. Иммундыглобулиннің Ғаб фрагменті бос болып еді және спецификалық антигенмен байланысуы мүмкін. Осыған байланысты А протеин диагностикалық әдісте (коаглютинация) қолданылады.
Бактериофагтарға сезімталдығы (фаготип) тұрақты генетикалық сипаттамасына жатады, олар беткейлі рецепторларға негізделеді. Стафилококтардың көп штамдары лизогенді болып келеді. экзотоксиннен анатоксин дайындалады.

Патогенділік факторлары
Патогенділік факторлары микрокапсула, жасуша қабығының компоненттері, агрессия ферменттері таза, гиалуронидаза, липаза, плазмокоагулаза, лецетиназа, фибринолоизин, в лактамаза, гемолизин- в, г, ө) мен токсиндері (лейкоцидин, эксфолиатин, токсикалық шок синдромының токсині, еротоксиндер А, В, С, Е, Ғ) . Стафилококтар өте бейімделгіш болып келеді: антибактериалды препараттарға тұрақтылығы жылдам пайда болады. Трансдукцияланатын фаг комегімен жасушадан басқа жасушаға берілетін плазмидалар өте маңызды рөл атқарады. К-плазмидалар бір немесе бірнеше антибиотиктерге тұрақтылығын қадағалайды, сонымен қатар жасушадан тыс бетта-лактамаза ферментін бөліп бетта-лактамды қатарға жататын антибиотиктерді бұзады.



Резистенттілігі.
Стафилококтар қоршаған ортаға тұрақты болғандықтан, санитарлық биологияда олар ауаның санитарлық көрсеткіш микроорганизмі болып табылады. Стафилококтар кептіруге тұрақты, осы жағдайда вируленттілік қасиеттерін жоймайды, құрғақ ыстық әсерінен екі сағаттан соң жойылады, таза этанолға да тұрақты. Басқа антисептиктер және дезинфекциялық ерітінділердің әсеріне сезімтал келеді. Стафилококтар көптеген антибиотиктерге тұрақты болып келеді. Олардың негізгі себептері плазмидалар қадағалайтын бетта-лактамазаның түзілуі.

Эпидемиологиясы.
Стафилококтар адамның және жануарлардың қалыпты микрофлора өкілдері болып келеді. Соған байланысты ағзаның әртүрлі биотоптарында орналасады, көп мөлшерде теріде мекендейді.



Патогенезі және клиникасы
Стафилококгар басқа ШПМ секілді оппортунистгік аурулар тудырады. Стафилококтар этиологиялық фактор ретінде келесі нозологиялық аурулар тудырады: тері және теріасты жасушаларының аурулары (пиодермия, везикулопустулез, пемфигус, абсцесс, фурункул, карбункул, гидро- адениттер) ; тьіныс алу мушелерінің аурулары (баспа, плеврит, пневмония) ; жүйке жүйесі және сезіну мүшелерінің аурулары (менингит, отит, конъюнктивит ж. т. б. ) ; ауыз қуысы және асқорыту ағзаларының аурулары (стоматит, перитонит, парапроктит, энтерит, энтероколит, астан улану) ; сүйек-бүлшық ет жүйесі мен дәнекер тіннің аурулары (артриттер, периоститгер, остеомиелиттер ж. т. б. ) ; қан айналымы жүйесінің
пары (эндокардит, перикардит, флебитж. т. б. ) ; зәр шығаружыныс мүшелерініңаурулары (пиелит, цистит, рит, мастит, әндометрит, орхит ж. т. б. ) ; стафилококтық сепсис.



Иммунитеті
Стафилококтық инфекциялардан кейін барлық оппортунистік ауруларға тән жасушалық және гуморалды түрақсыз қарқынды емес иммунитет қалыптасады.



Жеделдетілген әдіс: ИФА, КоАР, ПЦР.
Бактериологияльщ әдіс: зерттеу материалы ретінде қан, ірің, қақырық, несеп, мүрын - жүтқыншақтың ышты қабығынан жағынды, қүсық массасы, нәжіс.
- Іс жүргізу
- Автоматтандыру, Техника
- Алғашқы әскери дайындық
- Астрономия
- Ауыл шаруашылығы
- Банк ісі
- Бизнесті бағалау
- Биология
- Бухгалтерлік іс
- Валеология
- Ветеринария
- География
- Геология, Геофизика, Геодезия
- Дін
- Ет, сүт, шарап өнімдері
- Жалпы тарих
- Жер кадастрі, Жылжымайтын мүлік
- Журналистика
- Информатика
- Кеден ісі
- Маркетинг
- Математика, Геометрия
- Медицина
- Мемлекеттік басқару
- Менеджмент
- Мұнай, Газ
- Мұрағат ісі
- Мәдениеттану
- ОБЖ (Основы безопасности жизнедеятельности)
- Педагогика
- Полиграфия
- Психология
- Салық
- Саясаттану
- Сақтандыру
- Сертификаттау, стандарттау
- Социология, Демография
- Спорт
- Статистика
- Тілтану, Филология
- Тарихи тұлғалар
- Тау-кен ісі
- Транспорт
- Туризм
- Физика
- Философия
- Халықаралық қатынастар
- Химия
- Экология, Қоршаған ортаны қорғау
- Экономика
- Экономикалық география
- Электротехника
- Қазақстан тарихы
- Қаржы
- Құрылыс
- Құқық, Криминалистика
- Әдебиет
- Өнер, музыка
- Өнеркәсіп, Өндіріс
Қазақ тілінде жазылған рефераттар, курстық жұмыстар, дипломдық жұмыстар бойынша біздің қор #1 болып табылады.



Ақпарат
Қосымша
Email: info@stud.kz